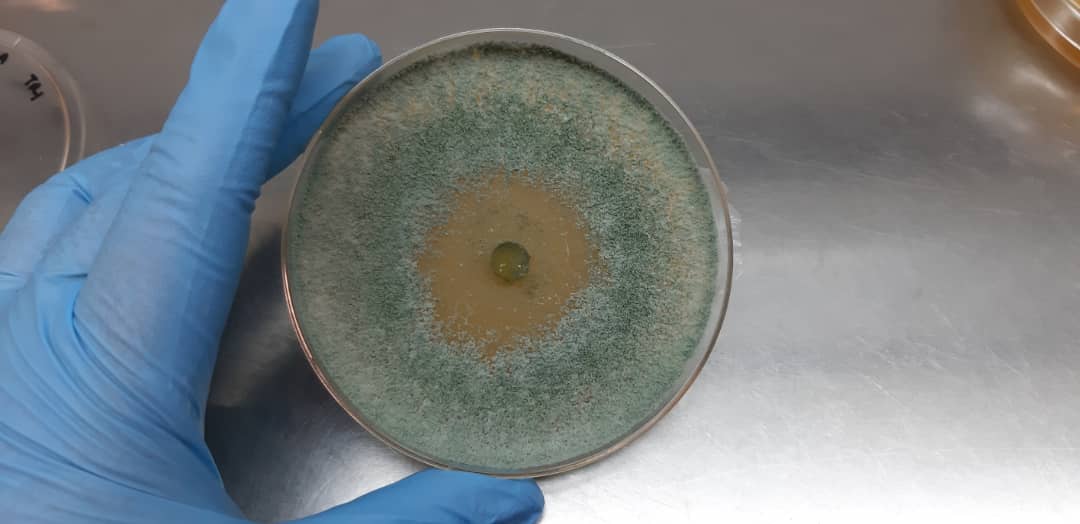
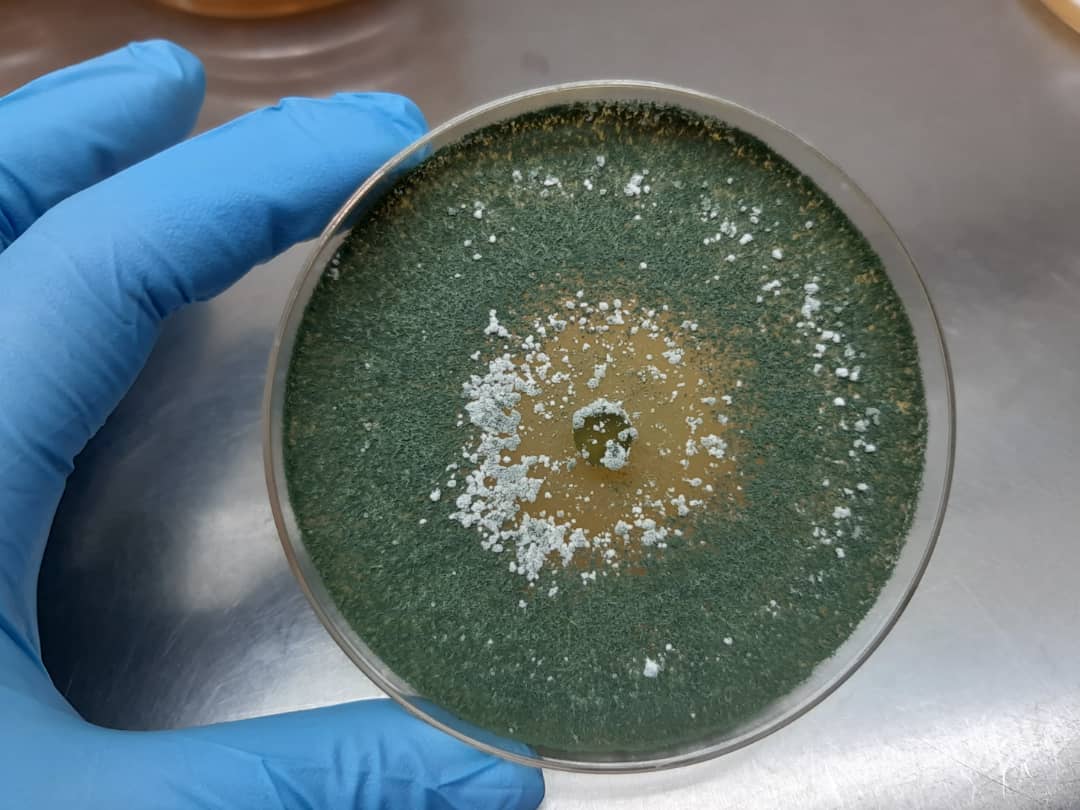

| Product Name | : | Trichoderma longibrachiatum | ||
| Type of Agreement | : | Sell and purchase | ||
| Principle/Leading Researcher | : | Prof. Ts. Dr. Chong Khim Phin | ||
| Novelty of Product | : | Biological control agent of oil palm basal stem rot disease. | ||
| Features of product | : | Pure culture of fungi in growing media. | ||
| Impact of product | : | Incorporated into production of fertilizer for the management of basal stem rot disease. | ||
| Target Market | : | Biofertilizer. | ||

| Product Name | : | UMS Eco-Solar Dryer | ||
| Type of Agreement | : | Licensing | ||
| Principle/Leading Researcher | : | Assoc. Prof. Dr. Jidon Adrian Janaun. | ||
| Novelty of Product | : | The aeration in the drying chamber can be switched between updraft and downdraft modes. | ||
| Features of product | : | Drying capacity is 50 kg. Solar heat collector produce up to 65oC hot air in the drying chamber. Hybrid drying mode comes as optional feature for premium drying. | ||
| Impact of product | : | A green technology. Produce hygiene drying process. Ease to operate, and suitable for most of agricultural, marine, and industrial products. | ||
| Target Market | : | Drying of Fruits, vegetables, and fish. A household product and social entrepreneur. |








| Product Name | : | LAMB Biomass Dryer | ||
| Type of Agreement | : | Licensing | ||
| Principle/Leading Researcher | : | Assoc. Prof. Dr. Jidon Adrian Janaun | ||
| Novelty of Product | : | High drying uniformity, batch and continuous operation mode, effective and efficient drying | ||
| Features of product | : | Capacity of batch dryer per unit is 0.5 - 10 tonnes. Enclosed drying process. Flexible hwating mechanism (electrical, furnace, or steeam). Suitable for granular type materials such as paddy, pepper, corn etc | ||
| Impact of product | : | Efficient energy usage because the hot air is recycled, cleaner environment because the whole system is enclosed. Can be scaled up easily with multipication on the number of LAMB drums | ||
| Target Market | : | Paddy drying, black pepper drying, palm kernel shell dryers, industrial dryers |
















